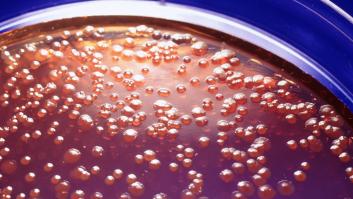
Un brote de salmonelosis en Badajoz deja 25 afectados, de ellos cinco hospitalizados

Qué se sabe del brote de salmonela en un festival en Galicia que ya deja 150 casos por España
Las autoridades sanitarias de la Xunta han descartado algunos casos inicialmente informados, pero elevan el número de hospitalizados tras lo que parece ser una intoxicación alimenticia masiva en el festival de Oza-Cesuras